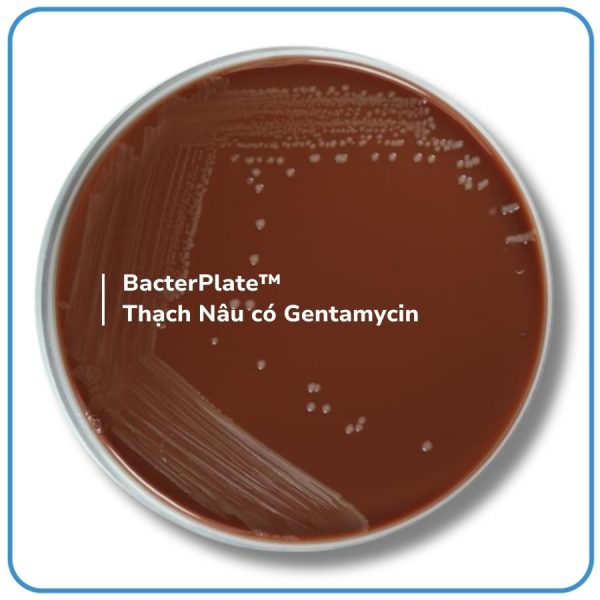

- BacterPlate™ Chocolate Agar (CAXV) is a highly enriched culture medium designed for the cultivation and isolation of fastidious microorganisms. It is commonly used in clinical microbiology and microbiological quality control testing. This medium supports the growth of organisms such as Haemophilus, Neisseria, Taylorella, and Campylobacter, which require specific growth factors (X and V factors). The heating process applied to the blood during preparation releases these essential factors, enhancing bacterial growth and facilitating diagnostic applications.
- The typical composition of base medium (Columbia Agar) corresponds to that defined in European (EP), United States (UP) and Japanese (JP) Pharmacopeias.
- The packaging with semi-permeable Cellophane film helps balance the humidity of the environment during storage.
PRINCIPLES
- Peptones included in the composition of the medium favor the excellent growth of colonies.
- Yeast extract is a source of vitamin B complex.
- Starch is a detoxifying agent and also an energy source.
- The heat treatment of blood in the medium lyses red blood cells, releasing growth factors such as hemin (X factor) and NAD (V factor), which are essential for the growth of certain bacteria.


 Tiếng Việt
Tiếng Việt